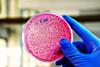
A,Scientist,Is,Holding,A,Plate,Of,E.,Coli,Growing

All Sequencing articles – Page 4
-
 News
NewsCapgemini’s AI innovation set to boost bioeconomy
Capgemini's new AI-powered methodology reduces data requirements by 99 percent and accelerates bioengineering breakthroughs, including improved plastic degradation and faster drug discovery.
-
 Article
ArticleUsing clinical genomics and AI in drug development to elevate success
How are clinical genomics and AI transforming drug development? Industry experts reveal how these technologies improve target identification, patient stratification, and trial design to drive higher success rates.
-
 News
NewsAzenta's BioArc Ultra powers UK research
UK Biocentre has significantly expanded its sample storage capacity with the addition of Azenta's BioArc Ultra, adding space for 16 million more samples to support vital health research.
-
 News
NewsGene linked to high altitudes could transform blood cancer therapy
Huntsman Cancer Institute researchers have identified a gene variant in Andean populations that could predict blood cancer treatment outcomes and potentially lead to targeted therapies.
-
 Article
ArticleAI paves the way for new immunotherapy targets
To fully unlock the potential of immunotherapy for cancer patients, we need better targets, not just better treatments. Hear from Michelle Teng, CEO of Etcembly, on how AI is decoding the immune repertoire and designing new therapies.
-
 News
NewsKey enzyme discovery marks a step forward in Alzheimer’s treatment
Scientists have decoded the 3D structure of a key enzyme linked to Alzheimer's disease. This breakthrough opens up new possibilities for targeted drug development and better treatment options.
-
News
NewsE. coli alters ribosomes to survive antibiotic treatment
New study shows E. coli resists antibiotics by modifying its ribosome structure, blocking drug binding and enabling growth despite treatment.
-
 News
NewsKRAS variants in human pancreatic cancer: new key findings
Researchers have identified underlying KRAS mutations which drive associated risk of particular clinical outcomes.
-
 News
NewsGenetic variants influencing SR B-ALL relapse risk identified
Genome and transcriptome sequencing revealed that subtypes such as TCF3/4::HLF were associated with an increased risk of relapse.
-
 News
NewsElucidating MDLC’s molecular features
The study’s results indicate that spatial sequencing of mixed-type breast cancers could inform personalised treatment.
-
 Article
ArticleHow MMR-deficient colorectal cancers regulate their growth
Understanding how MMR-deficient colorectal cancers drive tumour growth and avoid immune detection could pave the way for personalised cancer medicine.
-
 News
NewsMesothelial cells in omental adipose tissue hinder adipogenesis
The discovery that omental fat has a mechanism to limit adipocyte formation may lead to new treatments for obesity and metabolic disease.
-
 News
NewsExplaining uveal melanoma’s resistance to conventional immunotherapies
Researchers have developed a new tool called ‘Uveal Melanoma Immunogenic Score’ to predict which patients will respond to adoptive therapy.
-
 News
NewsDeveloping precision medicine for gestational diabetes
Researchers have identified that gestational diabetes is associated with a deficit in placental expression of IGFBP1.
-
 News
NewsAtlas of the human ovary offers huge potential for new treatments
Single-cell RNA sequencing of ovaries resulted in the identification of four major cell types and four immune cell subtypes.
-
 News
NewsRare genetic variants found to have a large impact on obesity risk
Researchers have gained a deeper understanding of the neural biology of obesity, which could offer potential drug targets.
-
 Whitepaper
WhitepaperCase Study: Target discovery for rheumatoid arthritis
Learn more about Euretos computational disease model and how it predicts many of the known drug targets for RA.
-
 News
NewsThe influence of the immune system on early human lung growth
Understanding the mechanisms in lung formation could develop new therapeutic approaches for respiratory conditions.
-
 News
NewsY chromosome discovery could advance personalised medicine
Researchers have completely decoded the human Y chromosome, which may result in more effective treatment for digestive disorders.
-
 Whitepaper
Whitepaperebook: Maximizing preclinical confidence in target efficacy and safety
This ebook outlines Euretos’ approach to target discovery and indication expansion. Whilst also discussing data-driven target selection.



